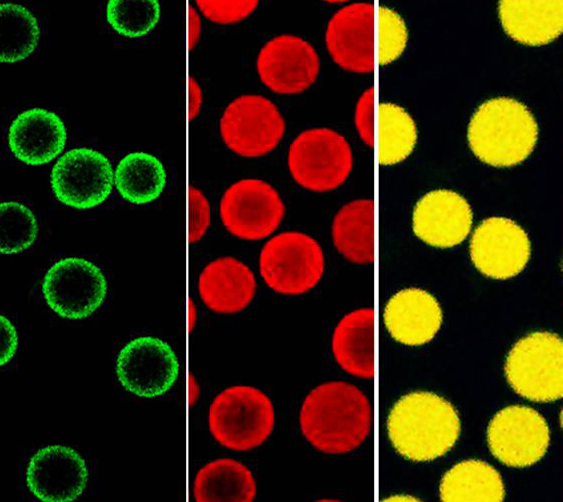
image.png

红色二氧化硅荧光微球
产品名称:红色二氧化硅荧光微球
产品描述:
单分散二氧化硅荧光微球是通过在单分散二氧化硅微球内部或表面上结合荧光分子制备而成,是我司最新开发出来的特色产品。
可提供红光、绿光等两种颜色。荧光微球具有荧光强度高、粒径分布窄、光学性能好、荧光染料不易泄露及表面可官能团化等特性,与高分子聚合物荧光微球相比,有更好的亲水性和生物相容性,可分散于水、乙醇等常见溶剂。
可广泛应用于荧光显微测定,共聚焦荧光显微测定,凝集反应等 各种荧光检测中,还可作为ELISA免疫分析、流体追踪、细胞追踪或吞噬作用研究。
二氧化硅微球主要特点
? 粒径尺寸的选择在1μm至10μm
? 可接受不同表面电荷以及不同规格大小的定制
? 极低的生物分子非特异性吸附;不吸附蛋白质,非常适用于免疫测定。
? 粒径高度均一(CV%小于5%),批间差小,重复性好
二氧化硅微球技术参数
? 成分: 二氧化硅(Silica Microspheres)
? 密度: 2.3 g/cm3
? 折射指数: 1.45 @ 589 nm (25°C)
激发波长:620nm
发射波长: 680nm
相关产品:
抗FITC荧光素抗体磁珠
山羊抗兔IgG抗体磁珠
山羊抗小鼠IgG抗体磁珠
鼠抗人IgG抗体磁珠
鼠抗兔IgG抗体磁珠
兔抗人IgG抗体磁珠
兔抗鼠IgG抗体磁珠
0.2ml八联排管磁力架
0.4ml/0.5ml磁力架
1.5ml磁力架/2ml磁力架
2ml磁力架(平底)
联系我们:
邮箱:2519696869@qq.com
QQ: 2519696869
电话:18066853083
微信:18066853083
公司介绍:
西安齐岳生物科技有限公司是集化学科研和定制与一体的高科技化学公司。业务范围包括化学试剂和产品的研发、生产、销售等。涉及产品为通用试剂的分销、非通用试剂的定制与研发,涵盖生物科技、化学品、中间体和化工材料等领域。
主营产品:COF、MOF单体系列:三蝶烯衍生物、金刚烷衍生物、四苯甲烷衍生物、peg、上转换、石墨烯、光电材料、点击化学、凝集素、载玻片、蛋白质交联剂、脂质体、蛋白、多肽、氨基酸、糖化学等。


